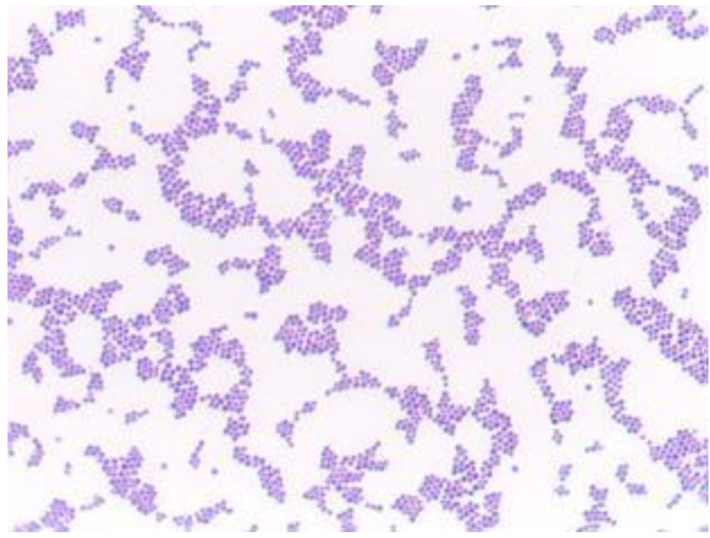
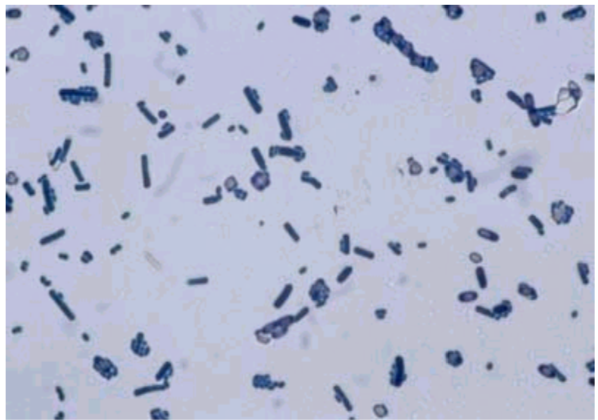
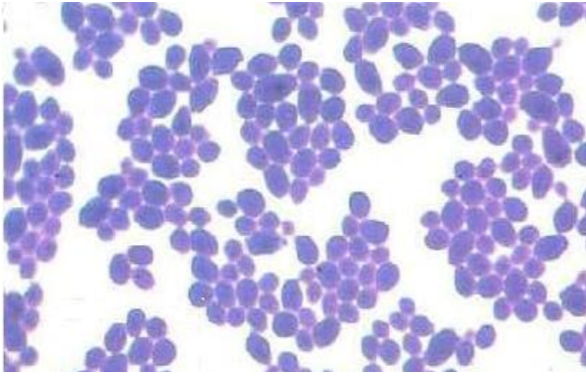
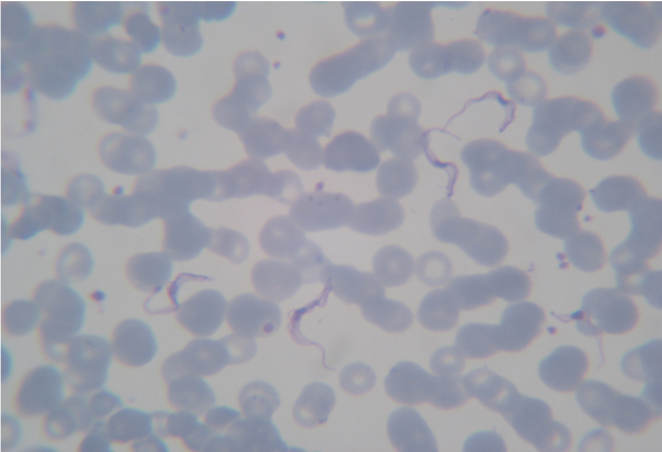

Staphylococcus aureus

Streptococcus pyogenes

Streptococcus pneumoniae

Neisseria

E. coli

Haemophilus influenzae

Bacillus cereus
Clostridium perfringens (Gas gangrene)

Clostridium tetani
Gram positive rods, spores are terminal cells look like drumsticks

Corynebacterium diphtheriae

Neisseria gonorrhoeae in pus
Candida albicans from culture
(similar to s. aureus, but fatter)

Trichomonas vaginalis and soor (Candida albicans) positive vaginal smear

Leptospira sp.

Mycobacterium tuberculosis in sputum

Plasmodium falciparum
Trypanosoma brucei

Enterobius vermicularis eggs